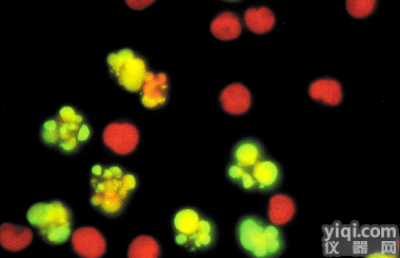
人小气道<em>上皮</em><em>细胞</em>ATCC厂商代理<em>细胞</em><em>价格优惠</em>

人神经上皮瘤细胞SK-N-MC [SKNMC] 价格优惠
- 产地:其它
- 供应商:上海鑫闵生命科技有限公司
- 供应商报价:1900
- 标签:人神经上皮瘤细胞SK-N-MC [SKNMC] 价格优惠,生物试剂,通用试剂,供应人神经上皮瘤细胞SK-N-MC [SKNMC] 价格优惠,上海鑫闵生命科技有限公司
产品名称:人神经上皮瘤细胞 SK-N-MC [SKNMC]
规格:1*10的6次方
价格:1900
本公司长期经营:细胞株、菌种、Elisa试剂盒、生化试剂、抗体等产品种类齐全、现货供应,欢迎各位新老客户选购,“人神经上皮瘤细胞 SK-N-MC [SKNMC]”详细资料请联系在线客服。
人神经上皮瘤细胞 SK-N-MC [SKNMC],相关产品:
小鼠单核巨噬细胞 J774A.1
小鼠肾集合管细胞(含SV40病毒序列) M-1
人侵袭性脉络膜黑色素瘤细胞 M619
狗肾细胞隆突型 MDCK superdome
小鼠前胃癌细胞(绿色荧光蛋白标记) MFC-GFP
人胃癌细胞 MGC-803 [MGC803]
人子宫颈癌细胞(GFP基因修饰) HeLa-GFP
人胃癌细胞 MKN-45
小鼠肾足细胞(含tsSV40T序列) Mouse podocyte
人侵袭性脉络膜黑色素瘤细胞 MuM-2B
人侵袭性脉络膜黑色素瘤细胞 MuM-2C
人肺黏液上皮样癌细胞 NCI-H292
人低侵袭性脉络膜黑色素素瘤细胞 OCM-1A
小鼠淋巴瘤细胞 P388D1(IL-1)
人胃腺癌细胞 SGC-7901 [SGC7901]
人低分化肺腺癌细胞 SK-LU-1 [SKLU-1;SKLU1]
小鼠子宫颈癌细胞 U14
小鼠子宫颈癌细胞(绿色荧光蛋白标记) U14-GFP
人乳腺导管癌细胞 ZR-75-30 [ZR7530]
人急性T淋巴细胞性白血病细胞 I 2.1
人膀胱癌细胞
人肾透明细胞腺癌细胞 786-O [786-0]
人肾透明细胞癌 Caki-1
人导管癌细胞 CFPAC-1
人食管癌细胞 EC109
人结直肠腺癌细胞 HCT-15 [HCT15]
人结直肠腺癌细胞 LS 174T [LS174T]
人乳腺癌细胞 MDA-MB-468
小鼠浆细胞瘤 MPC-11
人肺支气管癌细胞 NCI-H1650
人非小细胞肺腺癌细胞 NCI-H1975
人非小细胞肺腺癌细胞 NCI-H2087
人小细胞肺癌细胞 NCI-H2227
人非小细胞肺癌细胞 NCI-H23
人肾上腺皮质腺癌细胞 NCI-H295R
人肺腺鳞癌细胞 NCI-H596
人非小细胞肺癌细胞 NCI-H838
人食管癌细胞 NEC
小鼠胚胎成纤维细胞 PA317
人膀胱鳞癌细胞 SCaBER
人肺鳞癌细胞 SK-MES-1 [SKMES-1;SKMES1]
人神经上皮瘤细胞 SK-N-MC [SKNMC]
人甲状腺鳞癌细胞 SW579 [SW 579;SW-579